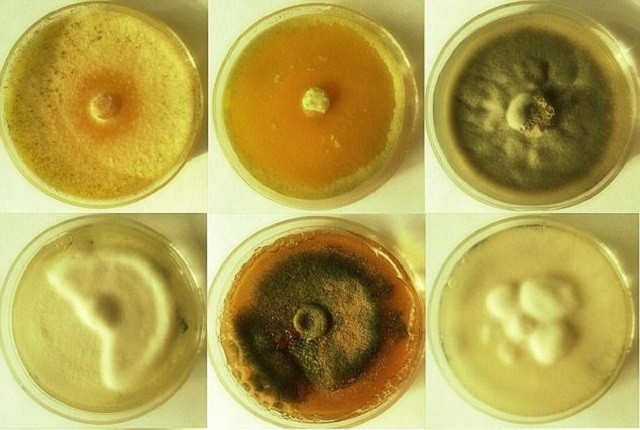
Loài nấm Trichoderma reesei. Ảnh: Daily Mail.

Khối bê tông bị hư hỏng theo thời gian có thể gây ra mối đe dọa lớn cho những công trình kiến trúc dù chỉ là những vết nứt nhỏ. Để loại bỏ được vấn đề này, mới đây, các nhà khoa học đã sáng chế ra một loại bê tông có thể tự hàn gắn vết nứt bằng cách trộn một số chất và một loại nấm có tên là Trichoderma reesei.
Theo Congrui Jin, trợ lý giáo sư về ngành kỹ thuật cơ khí tại Đại học Binghamton (Mỹ), nếu như không được sửa chữa kịp thời, các vết nứt trên bê tông sẽ ngày càng lan rộng khiến việc trùng tu công trình càng trở nên tốn kém hơn.
Ông này nói thêm, khi các vết nứt này tiếp xúc với cốt thép bên trong khối bê tông sẽ gây ra quá trình oxy hóa, ăn mòn do tiếp xúc với nước, carbondyoxide, choride… Điều này sẽ dẫn tới sự sụp đổ hoàn toàn của công trình cả bên ngoài lẫn bên trong.
 Congrui Jin cùng cộng sự. Ảnh: Daily Mail.
Congrui Jin cùng cộng sự. Ảnh: Daily Mail.Đây có thể là mối nguy hiểm lớn như trong trường hợp khối bê tông dùng để che chắn bức xạ ở trong các nhà máy điện hạt nhân. Nghĩ tới viễn cảnh, các khối bê tông này bị nứt và các tia xạ vượt ra ngoài sẽ gây những hậu quả nghiêm trọng đến mức nào.
Ông Jin còn cho biết thêm, việc thay khối bê tông cũ cũng chỉ là biện pháp ngắn hạn, vết nứt rồi cũng sẽ xuất hiện trở lại.
Lấy ý tưởng từ khả năng tự chữa lành được những vết thương, vết bầm tím hay gãy xương của cơ thể con người, các nhà khoa học tiến hành tìm kiếm những giải pháp lâu dài đối với những khối bê tông bị nứt.
Trong quá trình nghiên cứu, các nhà khoa học đã phát hiện ra một bằng chứng quan trọng, đó là nấm Trichoderma reesei khi trộn với bê tông sẽ trong trạng thái “ngủ”. Nhưng khi các vết nứt xuất hiện, oxy và nước len vào các kẽ nứt này.
Với một lượng đầy đủ oxy, nước, chất dinh dưỡng và số lượng nấm, Trichoderma reesei sẽ “tỉnh giấc”, các bào tử nảy mầm. Sự tăng trưởng này sẽ dẫn đến kết tủa Canxi Cacbonat và hàn gắn vết nứt.
Khi các vết nứt được lấp đầy, không có đủ dinh dưỡng cũng như oxy và nước, loại nấm trên lại trở về trạng thái “ngủ”.
Hiện tại, các nhà khoa học vẫn đang tiếp tục hoàn thiện công trình nghiên cứu trên thực nghiệm.